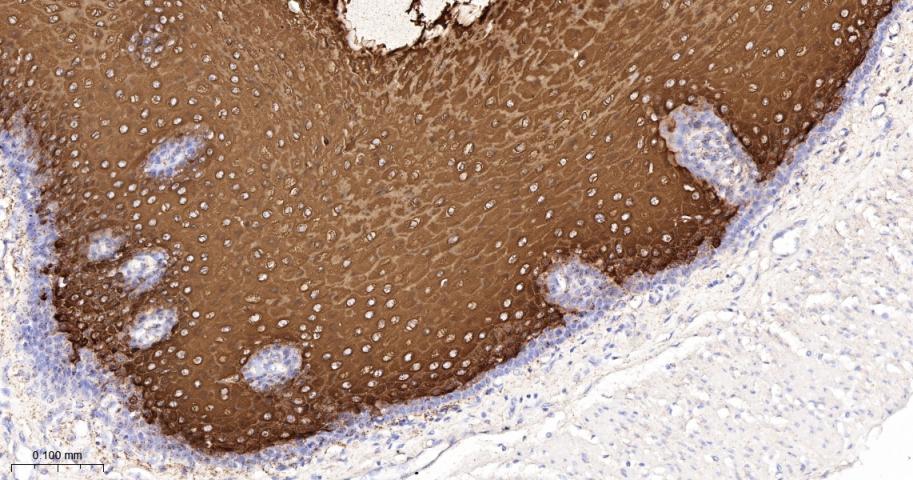
细胞角蛋白4重组兔单抗

Keratin 4 Recombinant Rabbit mAb (一抗) - IHC-P,IHC-F,IF | Bioss
Rrmab?兔单抗

货号:bsm-60219R
产品详情
相关标记
相关产品
相关文献
常见问题
概述
产品编号
bsm-60219R
产品类型
重组兔单抗、mIHC精品抗体
英文名称
Keratin 4 Recombinant Rabbit mAb
中文名称
细胞角蛋白4重组兔单抗
英文别名
K2C4_HUMAN; KRT4; Cytokeratin-4 (CK-4); Keratin-4 (K4); Type-II keratin Kb4; CYK4;
抗体来源
Rabbit
免疫原
KLH conjugated synthetic peptide derived from human Keratin 4
亚型
IgG
性状
Liquid
纯化方法
affinity purified by Protein A
克隆类型
Recombinant
克隆号
C2H9
理论分子量
57 kDa
浓度
1mg/ml
储存液
0.01M TBS (pH7.4) with 1% BSA, 0.02% Proclin300 and 50% Glycerol.
研究领域
SWISS
Gene ID
保存条件
Shipped at 4℃. Store at -20℃ for one year. Avoid repeated freeze/thaw cycles.
注意事项
This product as supplied is intended for research use only, not for use in human, therapeutic or diagnostic applications.
数据库链接
产品介绍
结构蛋白(Structural Proteins)
细胞角蛋白是一类与结构相关的蛋白家族,他们在上皮细胞中形成了细胞骨架中间丝。角蛋白在上皮细胞中往往成对存在,具有组织和细胞特异性。存在于口腔黏膜、鼻腔、食道和肛门生殖器上皮中的特异角蛋白为CK4和CK13。CK4是II型角蛋白,普遍存在于非角质化的鳞状上皮细胞中,CK4表达于基底细胞,也表达于鳞状细胞癌。
背景资料
The protein encoded by this gene is a member of the keratin gene family. The type II cytokeratins consist of basic or neutral proteins which are arranged in pairs of heterotypic keratin chains coexpressed during differentiation of simple and stratified epithelial tissues. This type II cytokeratin is specifically expressed in differentiated layers of the mucosal and esophageal epithelia with family member KRT13. Mutations in these genes have been associated with White Sponge Nevus, characterized by oral, esophageal, and anal leukoplakia. The type II cytokeratins are clustered in a region of chromosome 12q12-q13. [provided by RefSeq, Jul 2008]

产品应用
| 应用 | 已检合格种属 | 预测种属 | 推荐稀释比例 |
|---|---|---|---|
| IHC-P | Human, Mouse, Rat | 1:100-500 | |
| IHC-F | Human, Mouse, Rat | 1:100-500 | |
| IF | Human, Mouse, Rat | 1:100-500 |
交叉反应
交叉反应: Human, Mouse, Rat
相关产品
暂无相关产品
靶标
基因名
KRT4
蛋白名
Keratin, type II cytoskeletal 4
亚基
Heterotetramer of two type I and two type II keratins. Keratin-4 is generally associated with keratin-13.
组织特异性
Detected in the suprabasal layer of the stratified epithelium of the esophagus, exocervix, vagina, mouth and lingual mucosa, and in cells and cell clusters in the mucosa and serous gland ducts of the esophageal submucosa (at protein level). Expressed widely in the exocervix and esophageal epithelium, with lowest levels detected in the basal cell layer.
疾病
Defects in KRT4 are a cause of white sponge nevus of cannon (WSN) [MIM:193900]. WSN is a rare autosomal dominant disorder which predominantly affects non-cornified stratified squamous epithelia. Clinically, it is characterized by the presence of soft, white, and spongy plaques in the oral mucosa. The characteristic histopathologic features are epithelial thickening, parakeratosis, and vacuolization of the suprabasal layer of oral epithelial keratinocytes. Less frequently the mucous membranes of the nose, esophagus, genitalia and rectum are involved.
相似性
Belongs to the intermediate filament family.
同靶标产品
相关文献
提示: 发表研究结果有使用 bsm-60219R 时请让我们知道,以便我们可以引用参考文章。作为回馈,资料提供者将获得我们送上的小礼品。